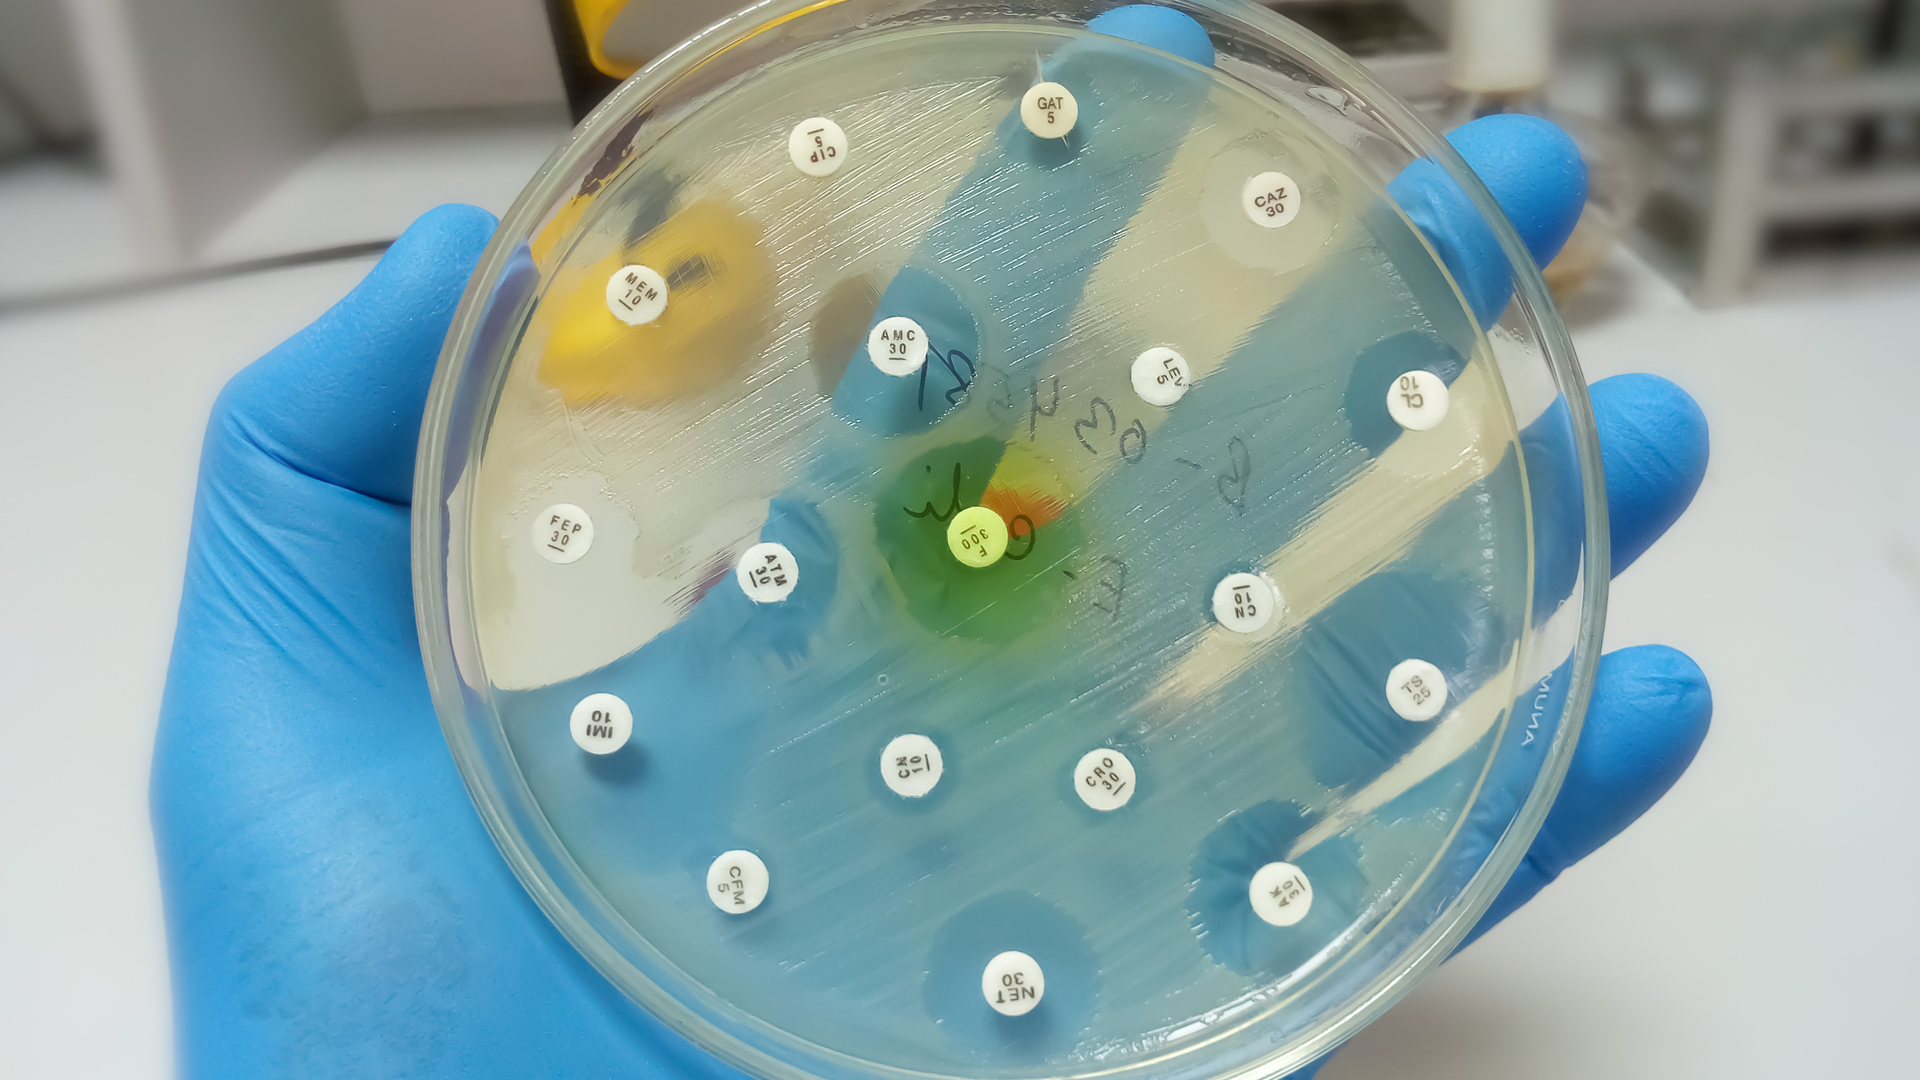

There’s an opportunity now for Canada to prevent the widespread growth of antimicrobial resistance (AMR). By moving ahead with an action plan as a follow-up to the antimicrobial resistance framework initially introduced five years ago, the Canadian government can dedicate funding for technology, diagnostics and surveillance.
By implementing the components of the 2017 framework, developed by the Public Health Agency of Canada, the Canadian government could get ahead of what many world leaders have dubbed a “silent pandemic.” These components include improving infection prevention, introducing stewardship programs and enabling more research innovation. It’s important to note that addressing AMR was a topic at the G7 summit this year, where those countries committed to the prudent and responsible use of antibiotics in human and veterinary medicine.
Antimicrobial resistance continues to have a devastating effect on people’s lives all over the world. According to the World Health Organization, AMR is one of the Top 10 global health threats facing humanity today. The threat continues because there aren’t concrete mechanisms in place to curtail it.
AMR means that bacteria, fungi, viruses or protozoa can void the effects of antimicrobial drugs (such as antibiotics), making those drugs ineffective. In 2018, more than one-quarter of bacterial infections in Canada were resistant to at least one antibiotic. Approximately 5,400 deaths were associated with AMR in the same year.
Canada has implemented two antimicrobial stewardship initiatives: the Northern Antibiotic Resistant Partnership and the Do Bugs Need Drugs program. However, public awareness remains low, as does engagement with key stakeholders such as practitioners, health service managers and policymakers.
The framework released five years ago, Tackling Antimicrobial Resistance and Antimicrobial Use: A Pan-Canadian Framework for Action, has as its primary components:
- Surveillance – providing strong, integrated systems for a comprehensive picture of AMR and antimicrobial use in Canada;
- Infection prevention and control – containing the spread of resistant organisms and reducing AMR and antimicrobial use with standardized programs and policies;
- Stewardship – raising awareness, and regulatory and professional oversight through programs and policies to reduce inappropriate use of antimicrobials;
- Research and innovation – developing new treatments, diagnostic tools and strategies, and raising awareness of resistance.
It’s anticipated that a pan-Canadian action plan will be released over the next year as a follow-up to the pan-Canadian framework. Included in that action plan will be the leadership, program and funding required to address the socioeconomic risks posed by AMR.
The long-term effects of AMR are already being felt and were made worse by COVID-19. AMR reduced labour productivity and GDP by $2 billion in 2018. The Public Health Agency of Canada reported that it spent $8.5 million per year between 2013-14 and 2016-17 for stewardship, surveillance and pan-Canadian co-ordination on AMS initiatives – indicating the government’s understanding of the potential severity of this public health issue.
Researchers also note that if we continue to overuse antibiotics as we are, the resistance rate will likely grow to 40 per cent by 2050 from 25 per cent in 2018, with annual deaths upwards of 13,700, compared to 5,400 in 2018.
Other G7 countries have taken steps towards proactively addressing AMR as a public health threat. From 2016 through 2020, the U.S. Centres for Disease Control and Prevention invested in more than 330 innovative antimicrobial resistance projects in more than 30 countries to slow the spread of resistance. The U.S. has also developed opportunities for increased public awareness.
From the archives: The global challenge of antimicrobial resistance
Canada can learn from other countries, from its own lessons from the pandemic and from accelerating efforts across the components identified in the AMR framework. This includes diagnostic testing resources, including quality laboratory supplies; training and human health resource capacity-building, and point-of-care infrastructure; addressing market-access challenges for innovative technology and medicines, and supporting networks for research, procurement and supply chain management; and bolstering surveillance capacity by improving health system IT infrastructure.
Technologies that encourage the appropriate use of antimicrobials and give them greater longevity must also be embraced. There isn’t enough technology to collect and analyze antimicrobial data.
This type of technology has the potential to form a multi-layered strategy in combatting AMR. For example, BD HealthSight was recently launched through a partnership between Eastern Health in Newfoundland and Labrador, and BD-Canada (which employs one of the authors of this article). It automates patient data from different hospital sources to help ensure patients receive the most effective medication for their illness or condition. It also identifies patients at risk of AMR and allows for early intervention.
The lack of efficiencies in Canada’s health-care system has come to the surface over the last few years. Technological innovations can enable health-care units across the country to improve response times and administrative efficiency while preventing human error.
To combat AMR and adhere to G7 commitments on AMR, the Canadian government must move forward to issue Canada’s AMR action plan, including investments in surveillance and new innovative solutions that can help address the issue head-on.